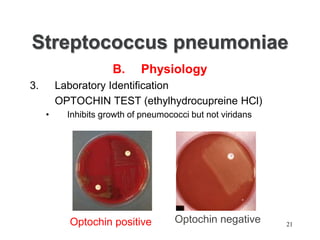
Streptococcus pneumoniae
B. Physiology
3. Laboratory Identification
OPTOCHIN TEST (ethylhydrocupreine HCl)
• Inhibits growth of pneumococci but not viridans
Optochin positive Optochin negative 21

Streptococcus pneumoniae, commonly known as pneumococcus, is a Gram-positive bacterium that is a major cause of pneumonia, meningitis, and sepsis. It was first isolated in 1881 by George Sternberg and Louis Pasteur. There are over 90 known serotypes of S. pneumoniae. It is a facultative anaerobe that is normally found in the upper respiratory tract of humans. Virulence factors include an antiphagocytic polysaccharide capsule and pneumolysin toxin. Diagnosis involves culture and identification of the bacterium from clinical specimens. Treatment involves antibiotics like penicillin, with vaccines available to help prevent pneumococcal disease.